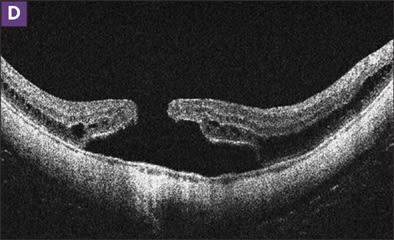

Treatment of Retinal Detachment Due to Macular Hole
The literature on how to manage this troubling outcome is inconclusive, 2 experts explain.
RON MARGOLIS, MD · STANLEY CHANG, MD
Retinal detachment associated with macular hole (MHRD) accounts for 0.5% of retinal detachments,1 although rates of 9% and 21% have been reported in the Japanese and Chinese literature, respectively.2,3 MHRD occurs predominantly in highly myopic eyes but has also been noted to occur after blunt ocular trauma. Although its pathophysiology is not fully understood, it is believed that MHRD in high myopia occurs due to 3 reasons: anteroposterior vitreous traction on the posterior pole due to a posterior staphyloma;4 tangential traction on the macula from contraction of the cortical vitreous and epiretinal membranes;5-7 and reduced retinal adherence to the choroid due to retinal pigment epithelial (RPE) atrophy.4
Various surgical procedures have been described in the treatment of MHRD. Although macular buckling was performed routinely prior to the advent of vitrectomy surgery, vitrectomy combined with peeling of the internal limiting membrane (ILM) and gas tamponade has become the most commonly chosen primary procedure. Better understanding of the tractional forces and advances in surgical techniques have increased reattachment rates from about 50% to over 90%. However, failure of macular hole closure and recurrent detachment remain challenging surgical problems, and visual outcomes are often disappointing. Reports in the literature are largely retrospective, making direct comparison of surgical methods difficult. The optimal treatment of MHRD has therefore remained controversial.
| Ron Margolis is a vitreoretinal fellow at the Columbia University College of Physicians & Surgeons. Stanley Chang, MD, is Edward Harkness Professor and Chair of the Department of Ophthalmology at Columbia University. Dr. Chang reports minimal financial interest in Alcon. Dr. Margolis reports no financial interests. Dr. Margolis can be reached via e-mail at ronmargolismd@gmail.com. |
PREOPERATIVE EVALUATION
Because vision loss in high myopia can be due to several reasons, the extent of chorioretinal atrophy, evidence of choroidal neovascularization, and glaucomatous optic neuropathy should be noted preoperatively. Clinical assessment of retinal anatomy and the vitreoretinal interface is difficult in highly myopic eyes with a posterior staphyloma. The thin retina and light coloration of the retinal pigment epithelium and choroid make it difficult to appreciate surface changes and thickening of the retina. Spectral-domain optical coherence tomography (SD-OCT) is invaluable in differentiating between a full-thickness macular hole, lamellar hole, and myopic foveoschisis. Epiretinal membranes causing a tractional retinal detachment may also be seen.8
VITRECTOMY
Gonvers and Machemer9 were the first to perform pars plana vitrectomy, partial air-fluid exchange, and face-down positioning for the treatment of MHRD. However, the procedure was not effective in eyes with a large posterior staphyloma and extensive areas of atrophy. Advances in surgical techniques have increased retinal reattachment rates and made vitrectomy the primary procedure of choice for most surgeons.
REMOVAL OF CORTICAL VITREOUS AND EPIRETINAL MEMBRANES
Detachment of the posterior hyaloid with complete removal of epiretinal membranes is essential for successful retinal reattachment. Stirpe and Michels first reported the presence of an epiretinal layer of adherent cortical vitreous in eyes with MHRD.6 Although a posterior vitreous detachment (PVD) may appear to be present and a vitreous opacity resembling a Weiss ring may be seen, an adherent layer of vitreous frequently remains adherent to the retinal surface due to schisis of the cortical vitreous.10,11 Use of intravitreal triamcinolone allows visualization of any remaining vitreous cortex.12 A diamond-dusted scraper is useful in brushing strands of vitreous from the surface of the retina. In some cases, there is a thick premacular vitreous structure overlying the macula and optic disc. An edge may be elevated and aspirated into the port using the vitreous cutter and then removed as a sheet. Grasping the layer with forceps often results in fragmented pieces that separate.
Histology of these membranes have shown a membrane made of loose collagen fibers consistent with vitreous cortex.11 Another injection of triamcinolone may identify a second membrane, made of fibroblast-like cells and collagen fibrils, which can be removed using the scraper or intraocular forceps. Several studies have reported a high failure rate in eyes in which these membranes were not removed completely.13,14
INTERNAL LIMITING MEMBRANE (ILM) PEELING
Recent attention has been focused on the role of tangential traction in the formation of myopic macular hole. Electron microscopy of surgical specimens shows myofibroblasts on the ILM, and contraction of these cells presumably results in tangential macular traction.15 Attempted removal of epiretinal membranes (ERM) alone does not appear to sufficiently relieve all tangential traction (Figure 1). Chen et al. achieved only a 50% reattachment rate with ERM peeling due to recurrence of membrane formation.16 ILM peeling is thought to be a definitive method of removing all overlying residual vitreous cortex, ERM, and cellular constituents. Complete removal of the ILM may also increase the flexibility of the detached retina that may counter the centrifugal stretching force caused by the posterior staphyloma. Studies in which eyes with MHRD were treated with vitrectomy, ILM peeling, and gas achieved retinal reattachment in over 90% of cases.15,17 Ueomoto et al. reported successful reattachment in 92.3% of eyes in which ILM was peeled vs 50% reattachment in eyes in which ILM was preserved.17 Lam et al. found that ILM peeling increased the odds of retinal reattachment, despite a relatively low overall reattachment rate of 63.2%.18




Figure 1. MHRD was repaired by vitrectomy with epiretinal membrane removal and C2F6 gas (A and B). The hole remained closed over 3 years of follow-up (C), although retinoschisis was developing (D). Residual membrane is visible in the nasal macula. Visual acuity improved from 20/400 to 20/40.
ILM peeling in highly myopic eyes is particularly challenging because the retina is detached and mobile, and the chorioretinal atrophy in a staphyloma makes visualization of the membrane difficult. Staining of the ILM with vital dyes can facilitate identification and peeling and avoid iatrogenic damage to the thin retina.15 Oie et al. reported that cases in which indocyanine green (ICG) was used to facilitate ILM peeling had a higher rate of retinal reattachment, macular hole closure, and better postoperative visual acuity compared to cases in which ILM peeling was performed without staining.19
We believe that complete ILM peeling is probably essential for macular hole closure and retinal reattachment in eyes with MHRD (Figure 2). Although we typically do not use ICG in idiopathic macular hole cases, we do find ICG staining helpful in those eyes with a posterior staphyloma. Fluid-air exchange is used to flatten the retinal detachment while gently draining the subretinal fluid through the macular hole. After flattening the retina, some saline is placed into the staphyloma, followed by a small amount of perfluorocarbon liquid to protect the bare RPE layer at the base of the hole. Then, a few drops of ICG are injected over the macula, and the dye is immediately aspirated. Although retinal toxicity due to ICG is a concern, we have not experienced this complication.


|

|
|

|
Figure 2. MHRD (A and B) was repaired by vitrectomy with epiretinal membrane removal and C2F6 gas (C). Three months later, the detachment recurred (D). Reoperation with internal limiting membrane peeling and gas repaired the detachment, although the macular hole remained open (E). Visual acuity improved from 20/400 to 20/200.
PHOTOCOAGULATION OF THE MACULAR HOLE
The use of endolaser photocoagulation of the macular hole rim has been found to increase the anatomic success rate by some,20 while other reports have shown no effect on retinal reattachment outcomes.21 Moreover, photocoagulation may further damage the macular photoreceptors and even result in gradually enlarging areas of chorioretinal atrophy, further limiting the recovery of functional visual outcome. We do not lase the macular hole in our patients.
AIR-FLUID EXCHANGE
Some authors have suggested that internal drainage of viscous subretinal fluid through the macular hole may lead to worse visual outcomes by damaging photoreceptors or enlarging the macular hole diameter.13 An alternative is to flatten the retina using heavy liquid and evacuate the fluid through a posterior retinotomy.23 We prefer to first drain subretinal fluid as completely as possible by aspirating through the macular hole. Then, a fluid-air exchange with the pressure set at a low rate can be used to express the remaining peripheral fluid posteriorly and aspirate until the retina is flat. We have not observed any complications from drainage of fluid through the hole.
INTRAOCULAR TAMPONADE
In our practice, we find that intraocular gas tamponade is effective in primary repair of MHRD when combined with complete removal of the ILM, and it avoids potential anterior-segment complications of silicone oil and the need for oil removal in a second procedure. Some studies on the use of gas tamponade have shown low success rates in comparison with silicone oil tamponade.13,18 The largest recent series of 57 eyes with MHRD that underwent repair using vitrectomy with C3F8 gas tamponade reported primary retinal reattachment in only 63.2% of eyes, and 84.2% reattachment after a second operation.18 However, ILM peeling was not performed uniformly. Studies that used ILM peeling and gas tamponade achieved primary reattachment in about 90% of cases.15,17,19 Although no difference in outcome has been reported between SF6 and C3F8, we prefer using the longer-acting C2F6 or C3F8 gases in all of our cases.
Silicone oil may be injected after an air-fluid exchange, by direct fluid-silicone exchange, or by perfluorocarbon liquid –oil exchange. The last method utilizes a drainage retinotomy to evacuate subretinal fluid and makes it possible to perform endolaser photocoagulation of the macular hole. The oil is removed after approximately 3 months using standard technique.
Wolfensberger and Gonvers treated 11 patients with laser photocoagulation of the macular hole and silicone oil tamponade for 3 months.22 After a mean follow up of 69 months, 10 eyes (91%) remained attached and 1 recurrence occurred after 11 years due to reopening of the hole. Scholda et al. achieved 100% primary reattachment rate using silicone oil tamponade without ILM peeling or photocoagulation of the hole.23 High-density silicone oil was used in conjunction with staining-assisted ILM peeling in 12 eyes, 10 (83%) of which had macular hole closure with retinal reattachment and 2 of which had reopening of the hole with recurrent detachment after oil removal.24
The small number of patients and variable surgical adjuncts used in each study make it difficult to draw conclusions regarding the efficacy of gas vs oil tamponade. Eyes with poor prognosis due to very deep staphyloma or marked chorioretinal atrophy, or in which complete ILM peeling cannot be performed, may benefit from prolonged tamponade of the macular hole. We prefer to use gas tamponade in primary repair and reserve silicone oil tamponade for repair of recurrent detachments.
MACULAR BUCKLE
Prior to the advent of vitrectomy, macular buckling was a standard surgical treatment for the repair of MHRD. Macular buckling changes the macular surface shape from extremely concave, due to a posterior staphyloma, to convex. The resulting convex surface alleviates both anteroposterior and tangential vitreous traction. Moreover, protrusion of the macula due to the buckling effect decreases axial length and myopia. Macular buckling also avoids cataract progression and iatrogenic peripheral retinal breaks, which are risks in vitrectomy.
Various macular explants have been described and found to be effective. However, a number of surgeons have noted that direct suturing of the explant to the posterior pole of the eye is very difficult, especially in Asian patients. The Ando plomb is a semirigid silicone plastic rod that measures 5 mm in width and varies in length.25,26 It is internally reinforced throughout its length by several titanium wires, with ridges at one end to facilitate suturing and a 5 mm diameter indenting head at the other. The titanium wires permit manual bending to obtain optimal positioning of the head on the posterior pole and ensure long-term retention of this configuration after implantation. The Ando plomb is sutured on the equatorial episclera without disinsertion of extraocular muscles, thereby avoiding passing sutures in the thinned staphylomatous sclera and reducing the risk of perforation. In reviewing his 17-year experience, Ando and colleagues reported retinal reattachment in 93.3% after primary surgery and 100% after secondary surgery.25 Furthermore, eyes that failed vitrectomy (without ILM peeling) were all repaired by macular buckling. Using a similar technique, Sasoh et al. achieved reattachment in 94% after primary surgery and 100% after secondary surgery.27
The technique of Ripandelli et al.13 requires detachment of the lateral rectus muscle and uses a solid silicone explant cut to 5 × 5 × 2 mm in size, secured with 6-0 braided nylon suture. Needles are passed into the sclera 5 mm above and below the macular hole, and drainage of subretinal fluid is performed using the suture needles. The sutures are tightened, and the explant is drawn into position over the macula and sutured directly on the posterior sclera. Using this technique, retinal reattachment and hole closure was achieved in 14 of 15 eyes with MHRD after primary surgery. In the same study, 7 of 11 eyes with successful reattachment after vitrectomy had persistence of macular hole.
Theodossiadis and Theodossiadis reported their experience with macular buckling over a mean follow-up of 15 years.28 Retinal reattachment and hole closure was achieved in 22 (88%) of eyes with 1 operation. Loosening of the scleral sutures with dislocation of the sponge occurred in 3 cases, which was resolved by resuturing the buckle. Ichibe et al.29 reported that, of 10 eyes undergoing vitrectomy with ILM peeling, the only eye that achieved macular hole closure was also treated with a macular buckle.
Studies that directly compare vitrectomy with macular buckling often report a higher rate of retinal reattachment in the macular buckling group. However, ILM peeling was either performed selectively or not at all in these studies. Overall, equally good reattachment rates of about 90% have been reported with either vitrectomy with ILM peeling or with macular buckling. Although we have not had any experience with macular buckling, the technique appears to have a role in the surgical treatment of MHRD, either as a primary procedure or in eyes with recurrent detachment after vitrectomy with membrane peeling.
SCLERAL SHORTENING
Anteroposterior scleral shortening has been accomplished by scleral infolding with or without scleral resection. Scleral resection has been combined with vitrectomy and gas tamponade for MHRD repair.30-32 In this method, a crescent-shaped lamellar scleral resection is performed temporally under the lateral rectus muscle. Mattress sutures are placed in the outer wound margins and are tightened, causing scleral infolding. In a simpler method that does not require resection, 6 mattress sutures are placed on the temporal side of the sclera, with 3 sutures in each of the superotemporal and inferotemporal quadrants. The sutures at an anteroposterior interval of 7 mm are placed as deep as possible, with posterior sutures located just anterior to vortex veins and fastened by infolding the sclera.33
The amount of scleral shortening depends on rigidity and thickness and varies significantly. Up to 4 mm of scleral shortening can result from either procedure with disappearance of the posterior staphyloma in many eyes. However, both techniques can induce astigmatism of as much as 5 D. When combined with vitrectomy, macular hole closure and retinal reattachment was achieved in the majority of eyes. These techniques may be considered in eyes with poor prognostic signs that have failed primary repair.
VISUAL ACUITY
As expected, visual results after MHRD repair depend on successful retinal reattachment and macular hole closure.34 The proportion of patients reported to experience an improvement in vision ranges from 38% to 100%, with most studies reporting an improvement in approximately 60% to 75% of patients. Even in eyes with macular hole closure and retinal reattachment, visual recovery is limited by the underlying chorioretinal atrophy. Although final visual acuity varies widely, mean postoperative vision is usually 20/200 or worse, and visual improvement is often not statistically significant relative to preoperative values.
Some studies compared MHRD repair using vitrectomy vs macular buckling and found better visual outcomes in the macular buckling group. Ripandelli et al.13 reported that the mean final visual acuity of 20/250 in the vitrectomy group and 20/110 in the macular buckling group. Visual improvement was significant only in the macular buckling group. Ando et al.25 reported that visual acuity improvement was significantly better after macular buckling (20/170) than after vitrectomy (20/450). Noncomparative studies in which vitrectomy with ILM peeling was performed reported visual outcomes similar to those of macular buckling.
CONCLUSIONS
The surgical management of MHRD is challenging and the optimal treatment remains controversial. The published literature suggests that a high rate of hole closure and retinal reattachment may be achieved by vitrectomy, complete removal of epimacular vitreous cortex and membranes with the assistance of triamcinolone, and extensive ILM peeling using staining with ICG or triamcinolone. A long-acting gas is usually sufficient for intraocular tamponade. Recurrent detachments may be managed by repeat vitrectomy with silicone oil tamponade and/or macular buckling. Scleral shortening has also been combined with vitrectomy in the management of MHRD, although few reports of this technique have been published. After retinal reattachment, an improvement in visual acuity may be expected in up to 75% of patients, although visual outcomes are limited by the underlying chorioretinal atrophy. RP
REFERENCES
- Margherio RR, Schepens CL. Macular breaks. 1. Diagnosis, etiology, and observations. Am J Ophthalmol. 1972;74:219.
- Minoda K. Retinal detachment due to macular hole among Japanese. Jpn J Ophthalmol. 1979;23:200.
- Zhang CF, Hu C. High incidence of retinal detachment secondary to macular hole in a Chinese population. Am J Ophthalmol. 1982;94:817-819.
- Morita H, Ideta H, Ito K, et al. Causative factors of retinal detachment in macular holes. Retina. 1991;11:281-284.
- Oshima Y, Ikuno Y, Motokura M, et al. Complete epiretinal membrane separation in highly myopic eyes with retinal detachment resulting from a macular hole. Am J Ophthalmol. 1998;126:669-676.
- Stirpe M, Michels RG. Retinal detachment in highly myopic eyes due to macular holes and epiretinal traction. Retina. 1990;10:113-114.
- Seike C, Kusaka S, Sakagami K, Ohashi Y. Reopening of macular holes in highly myopic eyes with retinal detachments. Retina. 1997;17:2–6.
- Ripandelli G, Parisi V, Friberg TR, Coppé AM, Scassa C, Stirpe M. Retinal detachment associated with macular hole in high myopia: using the vitreous anatomy to optimize the surgical approach. Ophthalmology. 2004;111:726-731.
- Gonvers M, Machemer R. A new approach to treating retinal detachment with macular hole. Am J Ophthalmol. 1982;94:468-472.
- Spaide RF, Fisher Y. Removal of adherent cortical vitreous plaques without removing the internal limiting membrane in the repair of macular detachments in highly myopic eyes. Retina. 2005;25:290-295.
- Sakaguchi H, Ikuno Y, Choi JS, Ohji M, Tano T. Multiple components of epiretinal tissues detected by triamcinolone and indocyanine green in macular hole and retinal detachment as a result of high myopia. Am J Ophthalmol. 2004;138:1079-1081.
- Yamamoto N, Ozaki N, Murakami K. Triamcinolone acetonide facilitates removal of the epiretinal membrane and separation of the residual vitreous cortex in highly myopic eyes with retinal detachment due to a macular hole. Ophthalmologica. 2004;218:248-256.
- Ripandelli G, Coppe AM, Fedeli R, et al. Evaluation of primary surgical procedures for retinal detachment with macular hole in highly myopic eyes: a comparison of vitrectomy versus posterior episcleral buckling surgery. Ophthalmology. 2001;108:2258-2265.
- Seike C, Kusaka S, Sakagami K, Ohashi Y. Reopening of macular holes in highly myopic eyes with retinal detachments. Retina. 1997;17:2-6.
- Kadonosono K, Yazama F, Itoh N, Uchio E, Nakamura S, Akura J, Sawada H, Ohno S. Treatment of retinal detachment resulting from myopic macular hole with internal limiting membrane removal. Am J Ophthalmol. 2001;131: 203-207.
- Chen YP, Chen TL, Yang KR, Lee WH, Kuo YH, Chao AN, Wu WC, Chen KJ, Lai CC. Treatment of retinal detachment resulting from posterior staphylomaassociated macular hole in highly myopic eyes. Retina. 2006;26:25-31.
- Uemoto R, Yamamoto S, Tsukahara I, Takeuchi S. Efficacy of internal limiting membrane removal for retinal detachments resulting from a myopic macular hole. Retina. 2004;24:560-566.
- Lam RF, Lai WW, Cheung BT, Yuen CY, Wong TH, Shanmugam MP, Lam DS. Pars plana vitrectomy and perfluoropropane (C3F8) tamponade for retinal detachment due to myopic macular hole: a prognostic factor analysis. Am J Ophthalmol. 2006;142:938-944.
- Oie Y, Emi K, Takaoka G, Ikeda T. Effect of indocyanine green staining in peeling of internal limiting membrane for retinal detachment resulting from macular hole in myopic eyes. Ophthalmology. 2007;114:303-306.
- Lu L, Li Y, Cai S, Yang J. Vitreous surgery in highly myopic retinal detachment resulting from a macular hole. Clin Experiment Ophthalmol. 2002;30:261-265.
- Kwok AK, Cheng LL, Gopal L, Sharma T, Lam DS. Endolaser around macular hole in the management of associated retinal detachment in highly myopic eyes. Retina. 2000;20:439-444.
- Wolfensberger TJ, Gonvers M. Long-term follow-up of retinal detachment due to macular hole in myopic eyes treated by temporary silicone oil tamponade and laser photocoagulation. Ophthalmology. 1999;106:1786-1791.
- Scholda C, Wirtitsch M, Biowski R, Stur M. Primary silicone oil tamponade without retinopexy in highly myopic eyes with central macular hole detachments. Retina. 2005;25:141-146.
- Cheung BT, Lai TY, Yuen CY, Lai WW, Tsang CW, Lam DS. Results of high-density silicone oil as a tamponade agent in macular hole retinal detachment in patients with high myopia. Br J Ophthalmol. 2007;91:719-721.
- Ando F, Ohba N, Touura K, Hirose H. Anatomical and visual outcomes after episcleral macular buckling compared with those after pars plana vitrectomy for retinal detachment caused by macular hole in highly myopic eyes. Retina. 2007;27:37-44.
- Tanaka T, Ando F, Usui M. Episcleral macular buckling by semirigid shaped-rod exoplant for recurrent retinal detachment with macular hole in highly myopic eyes. Retina. 2005;25:147-151.
- Sasoh M, Yoshida S, Ito Y, et al. Macular buckling for retinal detachment due to macular hole in highly myopic eyes with posterior staphyloma. Retina. 2000;20:445-449.
- Theodossiadis GP, Theodossiadis PG. The macular buckling procedure in the treatment of retinal detachment in highly myopic eyes with macular hole and posterior staphyloma: mean follow-up of 15 years. Retina. 2005; 25:285-289.
- Ichibe M, Yoshizawa T, Murakami K, Ohta M, Oya Y, Yamamoto S, Funaki S, Funaki H, Ozawa Y, Baba E, Abe H. Surgical management of retinal detachment associated with myopic macular hole: anatomic and functional status of the macula. Am J Ophthalmol. 2003;136(2):277-84.
- Matsumura M, Ogino N: A surgical approach for macular hole retinal detachment associated with high myopia. Jpn J Ophthalmic Surg. 1996;9:425–428.
- Shimizu E, Ohta T, Kogishi J, et al: Scleral resection for retinal detachment with macular hole after failure of intraocular gas. Jpn Rev Clin Ophthalmol. 1994; 88:1583–1586.
- Kono T, Takesue Y, Shiga S. Scleral resection technique combined with vitrectomy for a macular hole retinal detachment in highly myopic eyes. Ophthalmologica. 2006;220(3):159-63.
- Matsuo T, Shiraga F, Takasu I, Okanouchi T. Scleral infolding combined with vitrectomy and gas tamponade for retinal detachment with macular holes in highly myopic eyes. Jpn J Ophthalmol. 2001;45:403-408.
- Ikuno Y, Sayanagi K, Oshima T, Gomi F, Kusaka S, Kamei M, Ohji M, Fujikado T, Tano Y. Optical coherence tomographic findings of macular holes and retinal detachment after vitrectomy in highly myopic eyes. Am J Ophthalmol. 2003;136:477-481.








